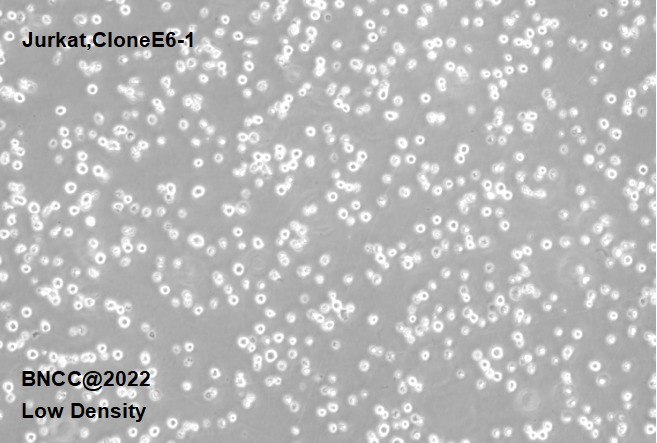

人T淋巴细胞白血病细胞
Jurkat,CloneE6-1
- BNCC338675
- BNCC
- 北京市
- 现货
- 按需
- 议价
- 2023-10-24 16:41:39
北京北纳创联生物技术研究院
一键申请试用
咨询
加入意向单
联系方式
- 英文名称
- Jurkat,CloneE6-1
人T淋巴细胞白血病细胞基本信息
| 培养基 | RPMI-1640完全培养基:85%RPMI-1640+15%FBS |
| 传代方法 | 复苏步骤:①冻存管从液氮或-80℃冰箱中取出放入PE手套中,迅速没入37℃水浴锅,摇晃冻存管加速溶解,以1min内全部溶解为宜;②在超净台中将溶解好的细胞液加入到装有9mL完全培养基的离心管内,1000-1200rpm离心3-5min,弃去上清液,用1-2mL完全培养基重悬细胞。③然后将细胞悬液加入到含有6-7mL完全培养基的T25瓶中,放入培养箱培养。培养瓶建议竖着培养。 细胞传代:①离心法:收集细胞,1000rpm离心5min,弃去上清液,补加1-2mL培养液后吹匀,将细胞悬液按1:2的比例分到新的含8mL培养基的T25瓶中。②半量换液法:可选择半量换液方式;请将上清培养基轻轻吸走一半,将剩余留有细胞沉淀的培养基重悬混匀,将细胞悬液按1:2的比例分到新的含8mL培养基的T25瓶中。③注意培养基pH值变化和细胞密度,定期换液(每周2-3次),待细胞密度达到大于2×106个/mL时,重复传代操作或者冻存。 |
| 生长条件 | 培养温度37℃;气体环境5%CO2+95%空气; |
| 生长特性 | 悬浮生长 |
| 存储条件 | 液氮 |
| 安全等级 | 1 |
| 形态 | 淋巴母细胞样,圆形,单个细胞,多数聚团 |
| 共享方式 | 公益性共享 |
支原体检测 |
为你推荐